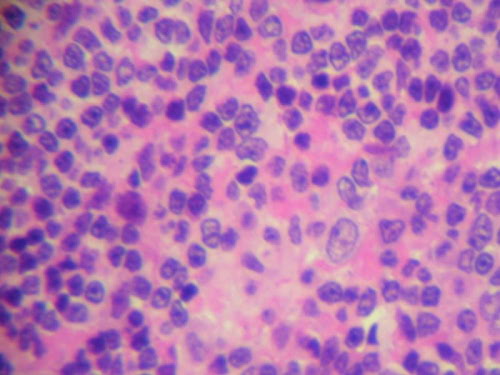

Nei pazienti con un tipo di linfoma, il linfoma a grandi cellule B diffuse, i livelli di vitamina D presenti nell'organismo sembrano essere strettamente collegati alla progressione del tumore ed alle probabilità di sopravvivenza.
I ricercatori della Mayo Clinic, uno dei più importanti centri di ricerca statunitensi, hanno scoperto questo legame molto evidente studiando 374 pazienti cui era stato in precedenza diagnosticato questo tipo di linfoma.
I test applicati sui pazienti hanno evidenziato come la metà di questi non avevano livelli di vitamina D sufficienti, e tra questi il rischio di una progressione del male è stata stimata essere superiore di 1,5 volte.
Una seconda parte della rilevazione, una volta aggiustati i parametri e tenuto conto di fattori che potessero influire sui risultati, ha infine evidenziato che il rischio di mortalità nei pazienti con bassi livelli di vitamina D è raddoppiato.
Il ruolo che la vitamina D potrebbe svolgere, nell’insorgere e nel progredire del cancro resta un dato sconosciuto, ma è noto, da precedenti ricerche e studi, che questa svolge un ruolo importante nella regolazione di crescita e morte delle cellule, processi di fondamentale importanza anche nella progressione tumorale.
Se questi risultati sono ancora molto ridotti nella loro importanza clinica, essi potrebbero però offrire un valido sostegno ad una possibile strategia terapeutica contro questa neoplasia, attuata attraverso la regolazione dei livelli di vitamina D.
Che, tra l’altro è relativamente semplice da ottenere: un’esposizione al sole d’estate per 15 minuti, 3 volte alla settimana sarebbe già sufficiente a riportare, insieme con integratori a basso costo, il livello di vitamina D nell’organismo ai livelli ottimali.
